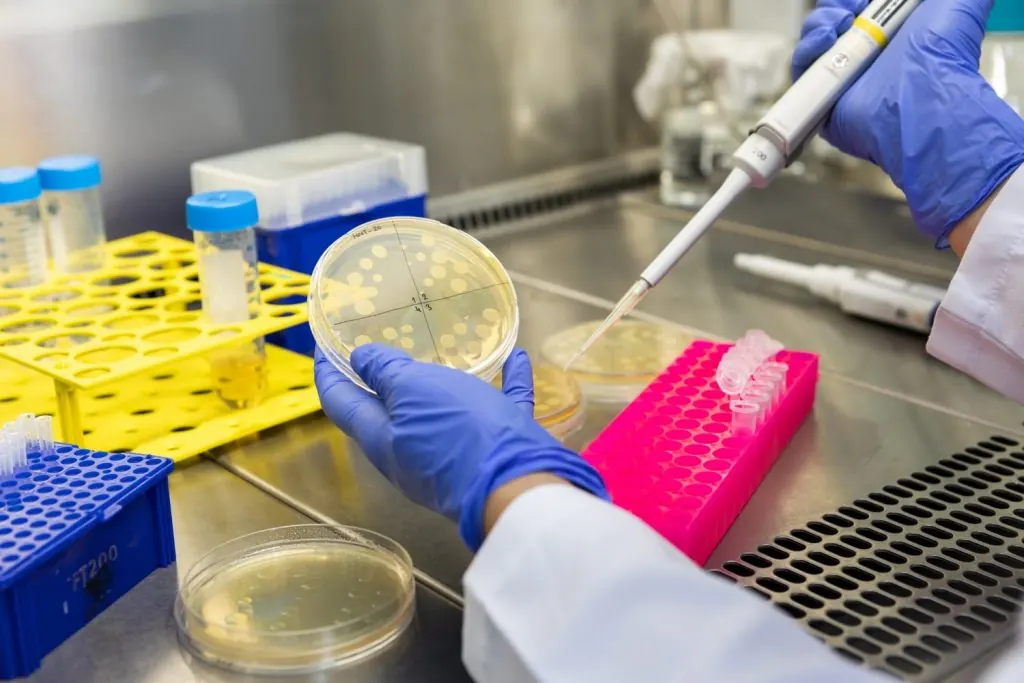
Mikrobiyoloji laboratuvarı görseli

Güvenilir üretim, güçlü AR-GE ve sürdürülebilir çözümler
DRN Kozmetik, 1984 yılından bu yana endüstriyel kimyasallar, su şartlandırma ve hijyen teknolojileri alanında faaliyet gösteren Deren Kimya’nın 40 yıllık bilgi birikimi ve üretim altyapısı üzerine kurulmuştur. Kozmetik sektörüne 2009 yılında adım atan şirketimiz, kozmetik üretim faaliyetlerini 2020 itibarıyla DRN Kozmetik çatısı altında birleştirerek büyüme sürecini güçlendirmiştir. 2024 yılında artan üretim kapasitesi ve genişleyen sözleşmeli üretim hizmetleri doğrultusunda ikinci fabrikamız devreye alınmıştır. Cilt bakımı, saç bakımı, kişisel bakım, ağız bakımı, el ve ayak bakımı kategorilerinde geniş bir ürün yelpazesi sunarken; endüstriyel temizlik ve araç bakım ürünleri üretimiyle de çok yönlü bir üretim altyapısına sahibiz. Pazar trendlerini ve marka ihtiyaçlarını analiz ederek AR-GE laboratuvarlarımızda yenilikçi formüller tasarlıyor, güçlü teknik altyapımızla markaların pazarda fark yaratmasını sağlayan yüksek standartlı kozmetik üretim çözümleri sunuyoruz. Kalite, güven ve müşteri odaklı yaklaşımımızla sağlık ve güzellik sektöründe uzun vadeli ve güvenilir bir üretim ortağı olmayı hedefliyoruz.

Vizyon
Misyon
Değerler
LABORATUVARLARIMIZ
AR-GE ve analiz altyapımız ile ürün geliştirme süreçlerinizi destekliyoruz.
AR-GE Laboratuvarı
Yenilikçi, güvenli ve yüksek performanslı kozmetik ürünler geliştirmek amacıyla tasarlanmış güçlü bir araştırma ve formülasyon merkezidir. Uzman kimyager ve formülasyon ekibimiz; cilt, saç ve kişisel bakım kategorilerinde trendleri, aktif içerikleri ve pazar ihtiyaçlarını analiz ederek özgün ürün formülleri tasarlamaktadır. Laboratuvarımızda formülasyon geliştirme, numune üretimi, stabilite ve performans testleri, ürün optimizasyonu ve mevzuata uygunluk çalışmaları titizlikle yürütülmektedir. Güçlü teknik altyapımız ve bilimsel yaklaşımımız sayesinde, markalara hızlı prototipleme ve güvenilir ürün geliştirme süreçleri sunuyoruz. DRN Kozmetik AR-GE Laboratuvarı, kalite, inovasyon ve sürdürülebilirlik ilkeleri doğrultusunda, markaların pazarda fark yaratan kozmetik ürünlerini hayata geçirmelerine destek olmaktadır.

Mikrobiyoloji Laboratuvarı
Deren Kimya San. ve Tic. A.Ş. bünyesinde 2005 yılında TÜBİTAK-TEYDEB Ar-Ge projesi desteği ve İstanbul Üniversitesi Genel Biyoloji Ana Bilim Dalı iş birliğiyle kurulmuştur. Laboratuvarımız, TS ISO 11731 standardına göre su sistemlerinde Legionella spp. tespiti ve sayımı gerçekleştiren yetkin bir analiz merkezidir. Evsel ve endüstriyel su sistemleri, oteller, hastaneler, plazalar, yüzme havuzları, spa merkezleri ve soğutma kulelerinden alınan numunelerde mikrobiyolojik analizler yaparak sistem suyu güvenilirliğini ve hijyenini değerlendirir, olası riskleri tespit ederiz. 20 yıllık tecrübemiz ve uzman kadromuzla, son teknolojiyle tasarlanmış laboratuvarımızda kozmetik ve su mikrobiyolojisi analiz hizmetleri sunmaktayız. Laboratuvarımız, TÜRKAK tarafından TS EN ISO/IEC 17025 standardına göre akredite olup, ulusal ve uluslararası ISO standartlarına tam uyumla çalışmaktadır. Bu akreditasyon, yalnızca bir belge değil; güvenilirliğimizin, profesyonelliğimizin ve kalite odaklı yaklaşımımızın resmi bir göstergesidir. İş ortaklarımıza en yüksek standartlarda analiz ve raporlama hizmeti sunmaktan gurur duyuyoruz.
ÜRETİM HATLARIMIZ
Farklı ürün tiplerine uygun modern dolum altyapısı
SERTİFİKALARIMIZ
Ulusal ve uluslararası standartlara uygun üretim






